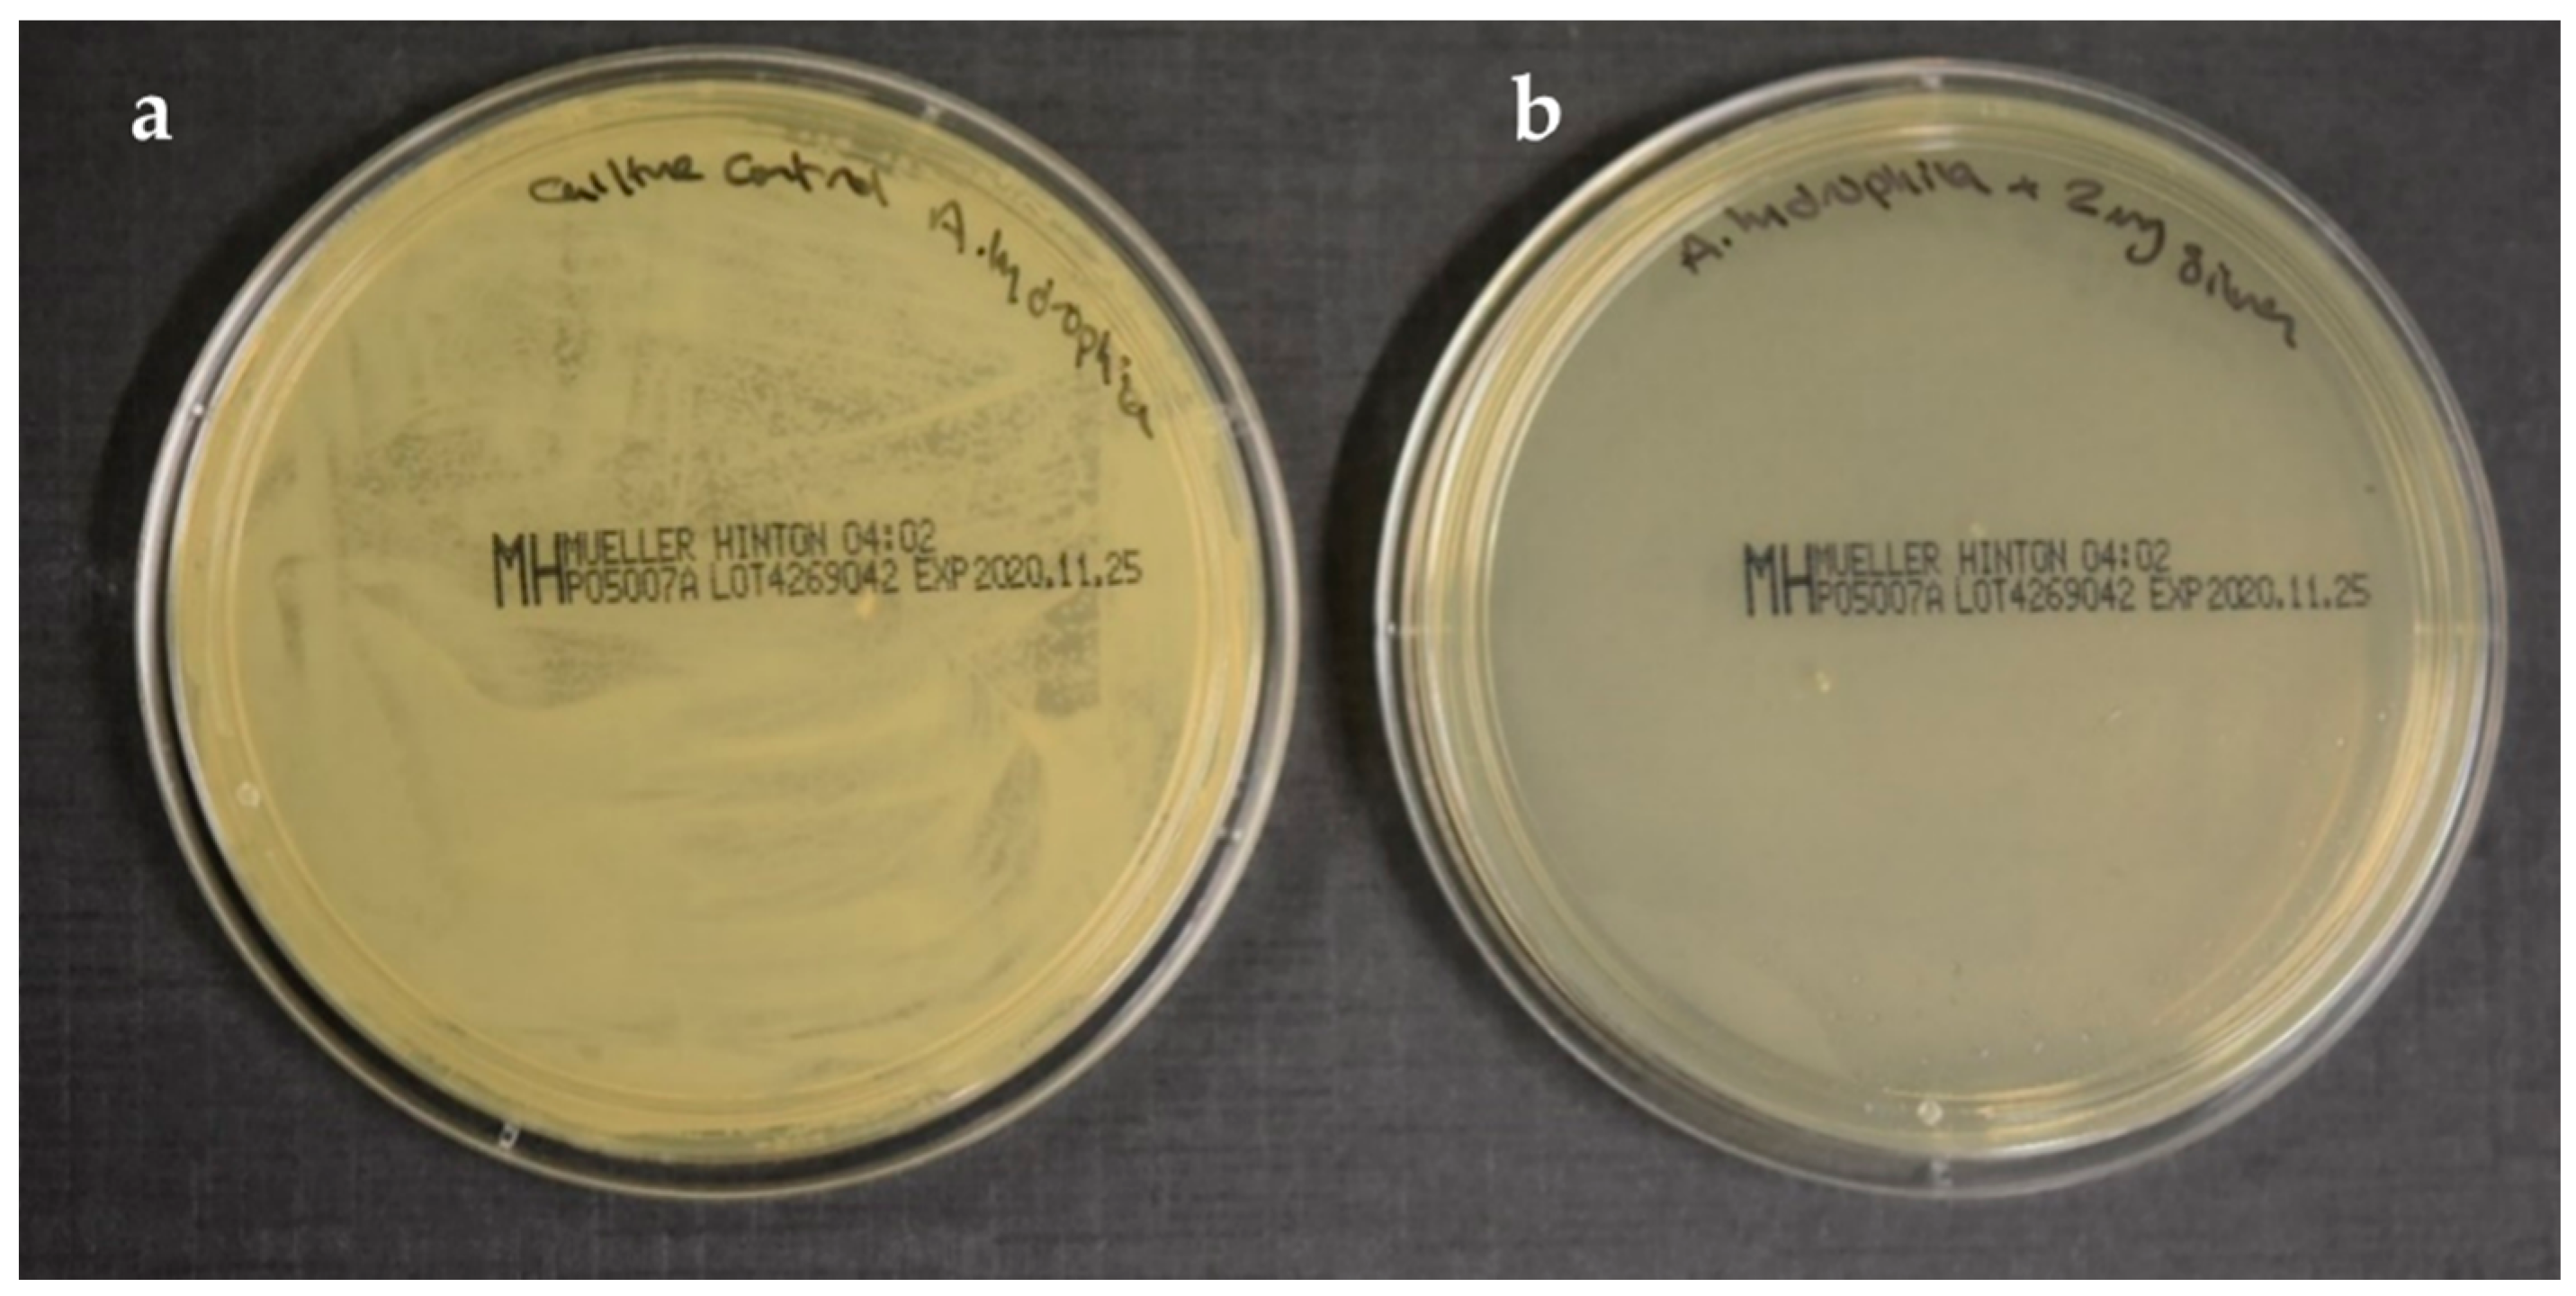
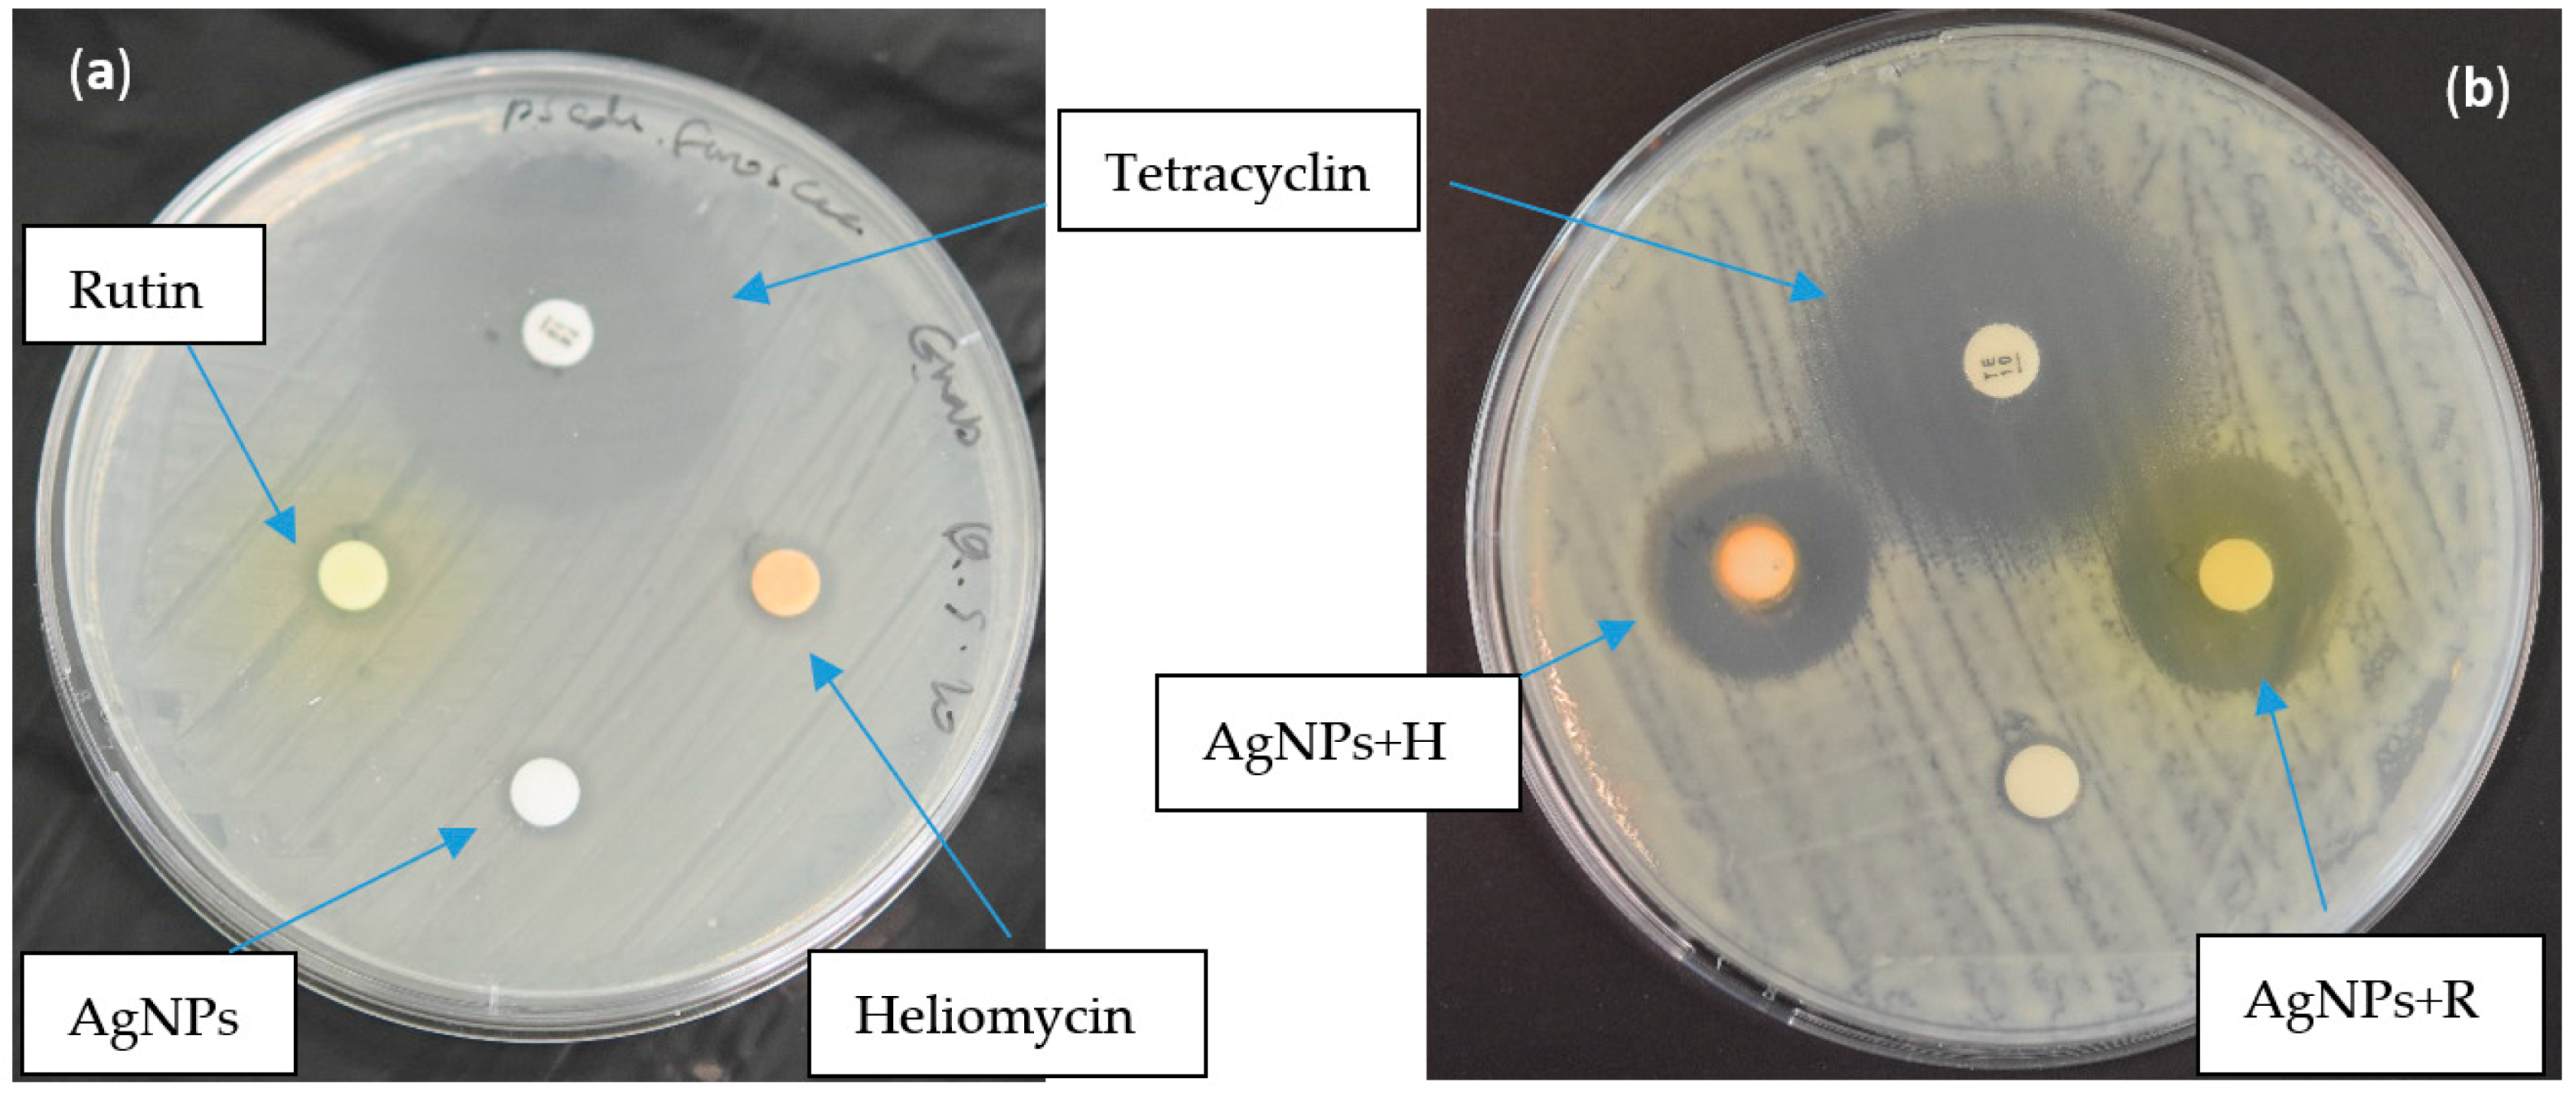

Synergistic Effect of Biosynthesized Silver Nanoparticles and Natural Phenolic Compounds against Drug-Resistant Fish Pathogens and Their Cytotoxicity: An In Vitro Study
Abstract
1. Introduction
2. Results
2.1. Characterization of the Biosynthesized AgNPs (Particle Size and Zeta Potential)
2.2. Antibacterial Effects of Bioactive Compounds
2.2.1. Minimum Inhibitory Concentration (MIC)
2.2.2. Determining Minimum Bactericidal Concentration (MBC)
2.2.3. Synergy Studies
2.2.4. Synergistic Effect Using the Disc Diffusion Method
2.2.5. Effect of Bioactive Compounds on Bacterial Growth
2.3. Cytotoxicity Assessment of Bioactive Compounds
2.3.1. Cell Morphology
2.3.2. Cell Viability Results
3. Discussion
4. Material and Methods
4.1. Extraction and Characterization of Rutin
4.2. Extraction and Characterization of Heliomycin
4.3. Biosynthesis and Characterization of Silver Nanoparticles (AgNPs)
4.4. Assessment of the Antibacterial Activities of AgNPs and Natural Phenolic Compounds
4.4.1. Bacterial Strains and Growth Conditions
4.4.2. Bacterial Growth Inhibition Assay
4.4.3. Minimum Inhibitory Concentration (MIC) Assay
4.4.4. Synergy Study
4.4.5. Disc Diffusion Method
4.4.6. UV–Visible Absorption
4.5. Cytotoxicity Assay
4.5.1. Fish Cell Lines and Culture Condition
4.5.2. Cell Morphology Examination
4.5.3. Cytotoxicity and Cell Viability Assessment
4.6. Statistical Analysis
5. Conclusions
Author Contributions
Funding
Institutional Review Board Statement
Informed Consent Statement
Data Availability Statement
Acknowledgments
Conflicts of Interest
References
- Suez, O. Bacteria associated with fresh-water aquaculture tilapia fish (Oreochromis niloticus) in Suez, Egypt. Food Sci. Nutr. Res. 2019, 2, 1–7. [Google Scholar]
- Karunasagar, I. Zoonoses—Infections Affecting Humans and Animals; Springer: Dordrecht, The Netherlands, 2015. [Google Scholar]
- Menanteau-Ledouble, S.; Lawrence, M.L.; El-Matbouli, M. Invasion and replication of Yersinia ruckeri in fish cell cultures. BMC Vet. Res. 2018, 14, 1–11. [Google Scholar] [CrossRef] [PubMed]
- Brown, P.; Dawson, M.J. A perspective on the next generation of antibacterial agents derived by manipulation of natural products. In Progress in Medicinal Chemistry; Elsevier B.V.: Oxford, UK, 2015; Volume 54, pp. 135–184. [Google Scholar]
- Stratev, D.; Odeyemi, O.A. Antimicrobial resistance of Aeromonas hydrophila isolated from different food sources: A mini-review. J. Infect. Public Health 2016, 9, 535–544. [Google Scholar] [CrossRef] [PubMed]
- Sellegounder, D.; Gupta, Y.R.; Murugananthkumar, R.; Senthilkumaran, B. Enterotoxic effects of Aeromonas hydrophila infection in the catfish, Clarias gariepinus: Biochemical, histological and proteome analyses. Vet. Immunol. Immunopathol. 2018, 204, 1–10. [Google Scholar] [CrossRef] [PubMed]
- Zhou, Z.J.; Zhang, L.; Sun, L. Pseudomonas fluorescens: Fur is required for multiple biological properties associated with pathogenesis. Vet. Microbiol. 2015, 175, 145–149. [Google Scholar] [CrossRef] [PubMed]
- Samayanpaulraj, V.; Velu, V.; Uthandakalaipandiyan, R. Determination of lethal dose of Aeromonas hydrophila Ah17 strain in snake head fish Channa striata. Microb. Pathog. 2019, 127, 7–11. [Google Scholar] [CrossRef]
- Shaalan, M.I.; El-Mahdy, M.M.; Theiner, S.; El-Matbouli, M.; Saleh, M. In vitro assessment of the antimicrobial activity of silver and zinc oxide nanoparticles against fish pathogens. Acta Vet. Scand. 2017, 59. [Google Scholar] [CrossRef]
- Saleh, M.; Kumar, G.; Abdel-Baki, A.A.; Al-Quraishy, S.; El-Matbouli, M. In vitro antimicrosporidial activity of gold nanoparticles against Heterosporis saurida. BMC Vet. Res. 2016, 12, 1–6. [Google Scholar] [CrossRef]
- Shaalan, M.; El-Mahdy, M.; Theiner, S.; Dinhopl, N.; El-Matbouli, M.; Saleh, M. Silver nanoparticles: Their role as antibacterial agent against Aeromonas salmonicida subsp. salmonicida in rainbow trout (Oncorhynchus mykiss). Res. Vet. Sci. 2018, 119, 196–204. [Google Scholar] [CrossRef]
- Saleh, M.; Abdel-Baki, A.A.; Dkhil, M.A.; El-Matbouli, M.; Al-Quraishy, S. Antiprotozoal effects of metal nanoparticles against Ichthyophthirius multifiliis. Parasitology 2017, 114, 1802–1810. [Google Scholar] [CrossRef]
- Ahmed, F.; Soliman, F.M.; Adly, M.A.; Soliman, H.A.M.; El-Matbouli, M.; Saleh, M. In vitro assessment of the antimicrobial efficacy of chitosan nanoparticles against major fish pathogens and their cytotoxicity to fish cell lines. J. Fish Dis. 2020. [Google Scholar] [CrossRef]
- Mao, B.H.; Chen, Z.Y.; Wang, Y.J.; Yan, S.J. Silver nanoparticles have lethal and sublethal adverse effects on development and longevity by inducing ROS-mediated stress responses. Sci. Rep. 2018, 8, 1–16. [Google Scholar] [CrossRef]
- Rajkumar, K.S.; Kanipandian, N.; Thirumurugan, R. Toxicity assessment on haemotology, biochemical and histopathological alterations of silver nanoparticles-exposed freshwater fish Labeo rohita. Appl. Nanosci. 2016, 6, 19–29. [Google Scholar] [CrossRef]
- Shati, A.A.; Elsaid, F.G. Biosynthesized silver nanoparticles and their genotoxicity. J. Biochem. Mol. Toxicol. 2020, 34, 1–7. [Google Scholar] [CrossRef]
- Orhan, D.D.; Özçelik, B.; Özgen, S.; Ergun, F. Antibacterial, antifungal, and antiviral activities of some flavonoids. Microbiol. Res. 2010, 165, 496–504. [Google Scholar] [CrossRef]
- Enogieru, A.B.; Haylett, W.; Hiss, D.C.; Bardien, S.; Ekpo, O.E. Rutin as a potent antioxidant: Implications for neurodegenerative disorders. Oxid. Med. Cell. Longev. 2018, 27, 1–17. [Google Scholar] [CrossRef]
- Gautam, R.; Singh, M.; Gautam, S.; Rawat, J.K.; Saraf, S.A.; Kaithwas, G. Rutin attenuates intestinal toxicity induced by Methotrexate linked with anti-oxidative and anti-inflammatory effects. BMC Complement. Altern. Med. 2016, 16, 1–6. [Google Scholar] [CrossRef]
- Arora, S.K. Molecular structure of heliomycin, an inhibitor of RNA synthesis. J. Antibiot. 1985, 38, 113–115. [Google Scholar] [CrossRef][Green Version]
- Fernandes, M.R.V.; Dias, A.L.T.; Carvalho, R.R.; Souza, C.R.F.; Oliveira, W.P. Antioxidant and antimicrobial activities of Psidium guajava L. spray dried extracts. Ind. Crop. Prod. 2014, 60, 39–44. [Google Scholar] [CrossRef]
- Vijayabharathi, R.; Bruheim, P.; Andreassen, T.; Raja, D.S.; Devi, P.B.; Sathyabama, S.; Priyadarisini, V.B. Assessment of resistomycin, as an anticancer compound isolated and characterized from Streptomyces aurantiacus AAA5. J. Microbiol. 2011, 49, 920–926. [Google Scholar] [CrossRef]
- Kock, I.; Maskey, R.P.; Biabani, M.A.F.; Helmke, E.; Laatsch, H. 1-Hydroxy-1-norresistomycin and resistoflavin methyl ether: New antibiotics from marine-derived streptomycetes. J. Antibiot. 2005, 58, 530–534. [Google Scholar] [CrossRef] [PubMed]
- Abdelfattah, M.S.; Elmallah, M.I.Y.; Faraag, A.H.I.; Hebishy, A.M.S.; Ali, N.H. Heliomycin and tetracinomycin D: Anthraquinone derivatives with histone deacetylase inhibitory activity from marine sponge-associated Streptomyces sp. SP9. 3 Biotech. 2018, 8. [Google Scholar] [CrossRef] [PubMed]
- Gołaś, I.; Szmyt, M.; Potorski, J.; Łopata, M.; Gotkowska-Płachta, A.; Glińska-Lewczuk, K. Distribution of pseudomonas fluorescens and aeromonas hydrophila bacteria in a recirculating aquaculture system during farming of European grayling (Thymallus thymallus L.) broodstock. Water 2019, 11, 376. [Google Scholar] [CrossRef]
- Abdel-Tawwab, M.; Razek, N.A.; Abdel-Rahman, A.M. Immunostimulatory effect of dietary chitosan nanoparticles on the performance of Nile tilapia, Oreochromis niloticus (L.). Fish. Shellfish Immunol. 2019, 88, 254–258. [Google Scholar] [CrossRef] [PubMed]
- Carew, A.C.; Hoque, M.E.; Metcalfe, C.D.; Peyrot, C.; Wilkinson, K.J.; Helbing, C.C. Chronic sublethal exposure to silver nanoparticles disrupts thyroid hormone signaling during Xenopus laevis metamorphosis. Aquat. Toxicol. 2015, 159, 99–108. [Google Scholar] [CrossRef]
- Cabello, F.C.; Godfrey, H.P.; Tomova, A.; Ivanova, L.; Dölz, H.; Millanao, A.; Buschmann, A.H. Antimicrobial use in aquaculture re-examined: Its relevance to antimicrobial resistance and to animal and human health. Environ. Microbiol. 2013, 15, 1917–1942. [Google Scholar] [CrossRef]
- Ghosh, S.; Patil, S.; Ahire, M.; Kitture, R.; Kale, S.; Pardesi, K.; Cameotra, S.; Bellare, J.; Dhavale, D.D.; Jabgunde, A.; et al. Synthesis of silver nanoparticles using Dioscorea bulbifera tuber extract and evaluation of its synergistic potential in combination with antimicrobial agents. Int. J. Nanomed. 2012, 7, 483–496. [Google Scholar]
- Mahanty, A.; Mishra, S.; Bosu, R.; Maurya, U.K.; Netam, S.P.; Sarkar, B. Phytoextracts-synthesized silver nanoparticles inhibit bacterial fish pathogen Aeromonas hydrophila. Indian J. Microbiol. 2013, 53, 438–446. [Google Scholar] [CrossRef]
- Carlson, C.; Hussein, S.M.; Schrand, A.M.; Braydich-Stolle, L.K.; Hess, K.L.; Jones, R.L.; Schlager, J.J. Unique cellular interaction of silver nanoparticles: Size-dependent generation of reactive oxygen species. J. Phys. Chem. B 2008, 112, 13608–13619. [Google Scholar] [CrossRef]
- Rao, C.; Kulkarni, G.U.; Thomas, P.J.; Edwards, P.P. Size-dependent chemistry: Properties of nanocrystals. Chem. Eur. J. 2002, 8, 28–35. [Google Scholar] [CrossRef]
- Ganeshpurkar, A.; Saluja, A.K. The Pharmacological Potential of Rutin. Saudi Pharm. J. 2017, 25, 149–164. [Google Scholar] [CrossRef] [PubMed]
- Deepika, M.S.; Thangam, R.; Vijayakumar, T.S.; Sasirekha, R.; Vimala, R.T.V.; Sivasubramanian, S.; Arun, S.; Babu, M.D.; Thirumurugan, R. Antibacterial synergy between rutin and florfenicol enhances therapeutic spectrum against drug resistant Aeromonas hydrophila. Microb. Pathog. 2019, 135. [Google Scholar] [CrossRef] [PubMed]
- Mahmoud, A.A.; Essawy, E.A.; Abdalla, M.S.; Abdelfattah, M.S. Production of heliomycin from Actinomycete and evaluation of its antimicrobial activities. J. Biosci. Appl. Res. 2019, 5, 429–437. [Google Scholar] [CrossRef]
- Nadysev, G.Y.; Tikhomirov, A.S.; Dezhenkova, L.G.; Shchekotikhin, A.E. Semi-synthetic derivatives of heliomycin with an antiproliferative potency. Recent Pat. Anticancer Drug Discov. 2018, 13, 469–472. [Google Scholar] [CrossRef] [PubMed]
- Loo, C.Y.; Rohanizadeh, R.; Young, P.M.; Traini, D.; Cavaliere, R.; Whitchurch, C.B.; Lee, W.H. Combination of silver nanoparticles and curcumin nanoparticles for enhanced anti-biofilm activities. J. Agric. Food Chem. 2016, 64, 2513–2522. [Google Scholar] [CrossRef]
- Barbinta-Patrascu, M.E.; Badea, N.; Pirvu, C.; Bacalum, M.; Ungureanu, C.; Nadejde, P.L.; Ion, C.; Rau, I. Multifunctional soft hybrid bio-platforms based on nano-silver and natural compounds. Mater. Sci. Eng. C 2016, 69, 922–932. [Google Scholar] [CrossRef] [PubMed]
- Fayaz, A.M.; Balaji, K.; Girilal, M.; Yadav, R.; Kalaichelvan, P.T.; Venketesan, R. Biogenic synthesis of silver nanoparticles and their synergistic effect with antibiotics: A study against gram-positive and gram-negative bacteria. Nanomed. Nanotechnol. Biol. Med. 2010, 6, 103–109. [Google Scholar] [CrossRef]
- Boyd, C.D.; Smith, T.J.; El-kirat-chatel, S.; Newell, P.D. Structural features of the Pseudomonas fluorescens biofilm adhesin LapA required for LapG-dependent cleavage, biofilm formation, and cell surface localization. J. Bacteriol. 2014, 196, 2775–2788. [Google Scholar] [CrossRef]
- Li, X.; Yeh, Y.C.; Giri, K.; Mout, R.; Landis, R.F.; Prakash, Y.S.; Rotello, V.M. Control of nanoparticle penetration into biofilms through surface design. Chem. Commun. 2015, 51, 282–285. [Google Scholar] [CrossRef]
- Önlü, S.; Saçan, M.T. An in silico approach to cytotoxicity of pharmaceuticals and personal care products on the rainbow trout liver cell line RTL-W1. Environ. Toxicol. Chem. 2017, 36, 1162–1169. [Google Scholar] [CrossRef]
- Nambi, K.S.N.; Majeed, S.A.; Taju, G.; Sivasubbu, S.; Babu, V.S.; Hameed, A.S.S. Effects of nicotine on zebrafish: A comparative response between a newly established gill cell line and whole gills. Comp. Biochem. Physiol. Part. C Toxicol. Pharmacol. 2017, 195, 68–77. [Google Scholar] [CrossRef]
- El Mahdy, M.M.; Eldin, T.A.S.; Aly, H.S.; Mohammed, F.F.; Shaalan, M.I. Evaluation of hepatotoxic and genotoxic potential of silver nanoparticles in albino rats. Exp. Toxicol. Pathol. 2015, 67, 21–29. [Google Scholar] [CrossRef]
- Farouk, M.M.; El-Molla, A.; Salib, F.A.; Soliman, Y.A.; Shaalan, M. The role of silver nanoparticles in a treatment approach for multidrug-resistant salmonella species isolates. Int. J. Nanomed. 2020, 15, 6993–7011. [Google Scholar] [CrossRef]
- Yang, J.; Guo, J.; Yuan, J. In vitro antioxidant properties of rutin. LWT Food Sci. Technol. 2008, 41, 1060–1066. [Google Scholar] [CrossRef]
- Abdelfattah, M.S.; Badr, S.E.A.; Lotfy, S.A.; Attia, G.H.; Aref, A.M.; Moneim, A.E.A.; Kassab, R.B. Rutin and selenium co-administration reverse 3-Nitropropionic acid-induced neurochemical and molecular impairments in a mouse model of huntington’s disease. Neurotox. Res. 2020, 37, 77–92. [Google Scholar] [CrossRef]
- Humphries, R.M.; Abbott, A.N.; Hindler, J.A. Understanding and addressing CLSI breakpoint revisions: A primer for clinical laboratories. J. Clin. Microbiol. 2019, 57. [Google Scholar] [CrossRef]
- Du, W.L.; Niu, S.S.; Xu, Y.L.; Xu, Z.R.; Fan, C.L. Antibacterial activity of chitosan tripolyphosphate nanoparticles loaded with various metal ions. Carbohydr. Polym. 2009, 75, 385–389. [Google Scholar] [CrossRef]
- Humphries, R.M.; Ambler, J.; Mitchell, S.L.; Castanheira, M.; Dingle, T.; Hindler, J.A.; Koeth, L.; Sei, K. CLSI methods development and standardization working group best practices for evaluation of antimicrobial susceptibility tests. J. Clin. Microbiol. 2018, 56, e01934-17. [Google Scholar] [CrossRef]
- Ali, S.W.; Rajendran, S.; Joshi, M. Synthesis and characterization of chitosan and silver loaded chitosan nanoparticles for bioactive polyester. Carbohydr. Polym. 2011, 83, 438–446. [Google Scholar] [CrossRef]
- Divya, K.; Vijayan, S.; George, T.K.; Jisha, M.S. Antimicrobial properties of chitosan nanoparticles: Mode of action and factors affecting activity. Fibers Polym. 2017, 18, 221–230. [Google Scholar] [CrossRef]
- Taju, G.; Majeed, S.A.; Nambi, K.S.N.; Hameed, A.S.S. Application of fish cell lines for evaluating the chromium induced cytotoxicity, genotoxicity and oxidative stress. Chemosphere 2017, 184, 1–12. [Google Scholar] [CrossRef]
- Thermofisher. Available online: https://assets.thermofisher.com/TFS-Assets/LSG/manuals/MAN0018369-alamarBlueHS-CellViabilityReagent-PI.pdf (accessed on 7 January 2021).
- Rampersad, S.N. Multiple applications of alamar blue as an indicator of metabolic function and cellular health in cell viability bioassays. Sensors 2012, 12, 12347–12360. [Google Scholar] [CrossRef] [PubMed]
- Dytham, C. Choosíng and Using Statístícs: A Biologist’s Guide, 3rd ed.; Wiley-Blackwell: Hoboken, NJ, USA, 2011; ISBN 9781405198387. [Google Scholar]

| Compound | Strain | MIC (μg/mL) | MBC (μg/mL) |
|---|---|---|---|
| Rutin | A. hydrophila | 1024 | 2048 |
| P. fluorescens | 1024 | 2048 | |
| Heliomycin | A. hydrophila | 2048 | (-) |
| P. fluorescens | 1024 | (-) | |
| AgNPs | A. hydrophila | 2 | 20 |
| P. fluorescens | 4 | 20 |
| Compound | Strain | Selected Sub-MIC (μg/mL) | Concentrations Used in Synergy Study (μg/mL) |
|---|---|---|---|
| Rutin | -A hydrophila. -P. fluorescens | R512, R256, R128, R64 | R 512 (μg/mL) + AgNPs 1 µg/mL R 256 (μg/mL) + AgNPs 1 µg/mL R 128 (μg/mL) + AgNPs 1 µg/mL R 64 (μg/mL) + AgNPs 1 µg/mL |
| Heliomycin | -A. hydrophila -P. fluorescens | H512, H256, H128, H64 | H 512 (μg/mL) + AgNPs 1 µg/mL H 256 (μg/mL) + AgNPs 1 µg/mL H 128 (μg/mL) + AgNPs 1 µg/mL H 64 (μg/mL) + AgNPs 1 µg/mL |
| AgNPs | -A. hydrophila -P. fluorescens | 1 |
| Strain | MICAgNPs/MIC R (Alone, µg/mL) | MICAgNPs/MIC R (in Combination, µg/mL) | FICI | Effect |
|---|---|---|---|---|
| A. hydrophila | 2/1024 | 1/64 | 0.562 | A |
| P. fluorescens | 4/1024 | 1/64 | 0.3125 | S |
| Strain | MICAgNPs/MIC H (Alone, µg/mL) | MICAgNPs/MIC H (in Combination, µg/mL) | FICI | |
|---|---|---|---|---|
| A. hydrophila | 2/2048 | 1/64 | 0.531 | A |
| P. fluorescens | 4/1024 | 1/64 | 0.3125 | S |
| Bioactive Compound | Strain | Zone of Inhibition |
|---|---|---|
| Rutin (512 µg/mL) | P. fluorescens | 9 ± 0.2 mm a |
| Heliomycin (512 µg/mL) | P. fluorescens | 8 ± 0.3 mm a |
| AgNPs (2 µg/mL) | P. fluorescens | 8 ± 0.1 mm a |
| AgNPs (2 µg/mL) + Rutin (512 µg/mL) | P. fluorescens | 23 ± 0.8 mm b |
| AgNPs (2 µg/mL) + Heliomycin (512 µg/mL) | P. fluorescens | 22 ± 0.5 mm b |
| Tetracycline (Positive Control) | P. fluorescens | 30 ± 0.1 mm c |
Publisher’s Note: MDPI stays neutral with regard to jurisdictional claims in published maps and institutional affiliations. |
© 2021 by the authors. Licensee MDPI, Basel, Switzerland. This article is an open access article distributed under the terms and conditions of the Creative Commons Attribution (CC BY) license (http://creativecommons.org/licenses/by/4.0/).
Share and Cite
Essawy, E.; Abdelfattah, M.S.; El-Matbouli, M.; Saleh, M. Synergistic Effect of Biosynthesized Silver Nanoparticles and Natural Phenolic Compounds against Drug-Resistant Fish Pathogens and Their Cytotoxicity: An In Vitro Study. Mar. Drugs 2021, 19, 22. https://doi.org/10.3390/md19010022
Essawy E, Abdelfattah MS, El-Matbouli M, Saleh M. Synergistic Effect of Biosynthesized Silver Nanoparticles and Natural Phenolic Compounds against Drug-Resistant Fish Pathogens and Their Cytotoxicity: An In Vitro Study. Marine Drugs. 2021; 19(1):22. https://doi.org/10.3390/md19010022
Chicago/Turabian StyleEssawy, Ehab, Mohamed S. Abdelfattah, Mansour El-Matbouli, and Mona Saleh. 2021. "Synergistic Effect of Biosynthesized Silver Nanoparticles and Natural Phenolic Compounds against Drug-Resistant Fish Pathogens and Their Cytotoxicity: An In Vitro Study" Marine Drugs 19, no. 1: 22. https://doi.org/10.3390/md19010022
APA StyleEssawy, E., Abdelfattah, M. S., El-Matbouli, M., & Saleh, M. (2021). Synergistic Effect of Biosynthesized Silver Nanoparticles and Natural Phenolic Compounds against Drug-Resistant Fish Pathogens and Their Cytotoxicity: An In Vitro Study. Marine Drugs, 19(1), 22. https://doi.org/10.3390/md19010022

